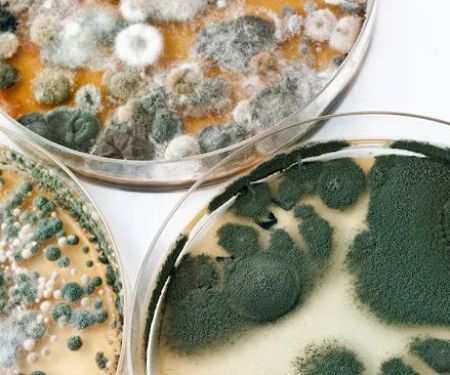
Prime

Waldorf Photos
Waldorf Introduce
Introduction / Overview: Your Trusted Local General Contractor in Waldorf, MD
When it comes to property maintenance, renovation, or unexpected disaster recovery, having a reliable and experienced general contractor by your side is essential. For homeowners and business owners throughout Charles County and the greater Southern Maryland region, especially those located in and around Waldorf, finding a local team that understands the community's needs and construction standards is a top priority. Waldorf, as a premier service provider in the area, operates as a dedicated general contractor, bringing professional expertise right to your doorstep.
Specializing in critical infrastructure and property care, this Waldorf-based contractor is distinctively focused on a highly necessary service for the Maryland community: water damage restoration. Maryland’s climate, with its heavy rain seasons, coastal proximity, and occasional severe weather events, makes residential and commercial properties susceptible to water intrusion, pipe bursts, and subsequent damage. This local business is equipped to manage the full scope of general contracting duties, ensuring that whether your project is an emergency restoration or a planned construction need, you receive comprehensive, high-quality service from start to finish. Our commitment is to restore not just your property, but also your peace of mind, with professional, efficient, and locally informed practices.
A general contractor acts as the central point of contact, managing all facets of a construction or restoration project, from initial assessment and planning to final completion and site cleanup. This oversight is particularly valuable in complex situations like water damage, which often requires coordination between demolition, drying, mold prevention, and reconstruction of affected areas like drywall, flooring, and insulation. By choosing a local Waldorf general contractor, you benefit from a singular team accountable for the entire process, minimizing stress and ensuring consistent quality control across all trades involved in the project. This integrated approach ensures that the reconstruction phase—the general contracting aspect—flows seamlessly from the initial restoration work, eliminating delays and communication gaps that can occur when multiple companies are involved.
The service focus on Water Damage Restoration means this contractor is uniquely prepared for time-sensitive, emergency situations. A water emergency can strike at any moment, from a burst basement pipe in the middle of the night to storm-related flooding. The urgency of water extraction and drying cannot be overstated, as standing water rapidly causes secondary issues like structural deterioration and mold growth, which is why a general contractor with this specialization is such an invaluable resource for the Waldorf community. We are not just repairmen; we are full-service restorers dedicated to bringing properties back to their pre-damage condition.
Location and Accessibility for Our Maryland Clients
This established contractor is conveniently situated in a high-traffic, central location, making it highly accessible for both emergency dispatch and client consultations throughout Waldorf and the surrounding Charles County communities. Our physical presence is a testament to our dedication to serving the local Maryland region.
The office is located at: 2670 Crain Hwy #419, Waldorf, MD 20601, USA.
Being directly on Crain Highway, a primary thoroughfare in Waldorf, ensures that our emergency response teams can mobilize quickly to address urgent water damage calls across Southern Maryland. For clients who need to visit the office for project planning or to review documentation, the location offers excellent accessibility. Furthermore, we understand the importance of making services available to everyone in the community. Our facility includes specific accommodations designed to ensure ease of access for all clients.
Services Offered – Specialist and Comprehensive Contracting
As a full-service general contractor with a specialization in water damage, the scope of work covers a broad range of construction, repair, and restoration needs. Our core expertise is centered around rapid response and thorough property recovery.
The primary services provided include:
- Water Damage Restoration Service: This is the core service, involving emergency water extraction, professional structural drying, dehumidification, and moisture monitoring to prevent secondary damage.
- Full-Scope General Contracting: Managing and executing all reconstruction required after damage, including drywall replacement, flooring installation, painting, and structural repairs.
- Post-Disaster Reconstruction: Comprehensive rebuilding services following water, storm, or other unforeseen damage events.
- Project Management: Coordinating all necessary subcontractors (plumbers, electricians, HVAC technicians, etc.) and managing timelines, permits, and inspections.
- Remediation Coordination: Working closely with specialized professionals (e.g., mold specialists) to ensure the environment is safe before reconstruction begins.
- Initial Damage Assessment and Documentation: Providing detailed reports and estimates to facilitate smooth insurance claims processing for Maryland residents.
- Residential and Commercial Restoration: Serving both homeowners and local Waldorf businesses with equal dedication and expertise.
Features and Highlights – Built for the Community
This Waldorf general contractor is distinguished by features that underscore a commitment to professionalism, client convenience, and community support in Southern Maryland.
Key features and service highlights include:
- Specialization in Water Damage Restoration: Deep expertise in this complex area of construction, ensuring effective and lasting repairs against one of Maryland's most common property threats.
- Wheelchair Accessible Entrance: A dedication to serving every member of the community by ensuring the main office entrance is easily accessible.
- Wheelchair Accessible Parking Lot: Providing convenient, reserved parking to make in-person consultations straightforward and stress-free for all clients.
- Local Maryland Focus: A business deeply rooted in Waldorf, providing services tailored to the specific construction codes and environmental challenges of Charles County, MD.
- Integrated Service Model: Offering the convenience of a single contractor to handle both the initial emergency restoration and the subsequent reconstruction and repair phases.
Contact Information
Reaching out to a trusted general contractor should always be simple, especially during a property emergency. This Waldorf-based team ensures multiple, easy-to-use channels for immediate contact.
Please use the following information to connect with us:
Address: 2670 Crain Hwy #419, Waldorf, MD 20601, USA
Primary Phone: (301) 547-7142
Mobile/Emergency Line: +1 301-547-7142
The provision of both a standard and a mobile line underscores the readiness to take emergency calls, which is critical for the rapid response required in water damage situations. Local Maryland residents can rely on a quick connection during their time of need.
What is Worth Choosing This General Contractor in Southern Maryland
Choosing the right contractor for your home or business in the Waldorf area is a major decision, particularly when dealing with the emotional and logistical stress of water damage. What truly sets this local business apart is the powerful combination of a specialized emergency service (Water Damage Restoration) delivered through the comprehensive, accountable framework of a General Contractor.
For Maryland property owners, this means you don’t have to hire one company to pump out the water and another to fix the hole in the wall. This Waldorf contractor handles the entire process, ensuring that the work is not only completed to a high standard but also that the crucial early steps—the drying and mold prevention—are managed by the same team that will be responsible for the final aesthetic finish. This integration drastically reduces project duration and overall hassle. The professional team ensures all work is compliant with local Charles County building regulations. Furthermore, the dedication to accessibility, evidenced by the wheelchair accessible entrance and parking, reflects a community-first business philosophy. When you choose Waldorf, you choose specialized expertise, all-in-one project management, and a local partner dedicated to serving the entirety of the Southern Maryland community with integrity and speed. This is more than just construction; it is complete property restoration managed with local care.
Waldorf Details
Accessibility
- Wheelchair accessible entrance
- Wheelchair accessible parking lot
Waldorf Location
Waldorf Reviews
More Water Damage Restoration Near Me
 Ready 2 Remodel5.0 (90 reviews)
Ready 2 Remodel5.0 (90 reviews)3261 Old Washington Rd Suite 2020, Waldorf, MD 20602, USA
Prime3.0 (37 reviews)
Prime3.0 (37 reviews)26 Industrial Park Dr, Waldorf, MD 20602, USA
 Scope, Inc4.0 (81 reviews)
Scope, Inc4.0 (81 reviews)6 Irongate Dr, Waldorf, MD 20602, USA
 SERVPRO of Charles County4.0 (107 reviews)
SERVPRO of Charles County4.0 (107 reviews)4441 Southern Business Park Dr, White Plains, MD 20695, USA
 Jenkins Restoration and Remodel4.0 (65 reviews)
Jenkins Restoration and Remodel4.0 (65 reviews)8352 Old Leonardtown Rd, Hughesville, MD 20637, USA
 C & C Complete Services4.0 (22 reviews)
C & C Complete Services4.0 (22 reviews)7327 Old Alexandria Ferry Rd, Clinton, MD 20735, USA
 ServiceMaster National Capital Restoration4.0 (184 reviews)
ServiceMaster National Capital Restoration4.0 (184 reviews)7551 Fordson Rd, Alexandria, VA 22306, USA
 1800 Packouts of DMV5.0 (1 reviews)
1800 Packouts of DMV5.0 (1 reviews)4901 Beech Pl suite b, Temple Hills, MD 20748, USA
 TBC Servs4.0 (100 reviews)
TBC Servs4.0 (100 reviews)29270 Three Notch Rd, Mechanicsville, MD 20659, USA
 Rainbow International4.0 (15 reviews)
Rainbow International4.0 (15 reviews)8423 Old Marlboro Pike, Upper Marlboro, MD 20772, USA
 Benko Disaster Restoration5.0 (13 reviews)
Benko Disaster Restoration5.0 (13 reviews)10816 Town Center Blvd, Dunkirk, MD 20754, USA
 Bay View4.0 (52 reviews)
Bay View4.0 (52 reviews)2800 Eisenhower Ave Suite 220, Alexandria, VA 22314, USA
Categories
Top Visited Sites
 PuroClean of Jacksonville Southbank4.0 (68 reviews)
PuroClean of Jacksonville Southbank4.0 (68 reviews) RestoPros of West Houston4.0 (35 reviews)
RestoPros of West Houston4.0 (35 reviews) Max Restoration4.0 (18 reviews)
Max Restoration4.0 (18 reviews) NRG Restoration LLC5.0 (79 reviews)
NRG Restoration LLC5.0 (79 reviews) Exact Recon4.0 (91 reviews)
Exact Recon4.0 (91 reviews) Erie, Inc.4.0 (71 reviews)
Erie, Inc.4.0 (71 reviews)Top Water Damage Restoration Searches
Trending Damage Repair Guides Posts
 How to Dry Your Home After a Major Water Leak: Essential Steps
How to Dry Your Home After a Major Water Leak: Essential Steps Water Damage Restoration Tips for Homeowners
Water Damage Restoration Tips for Homeowners How to Dry a Wet Carpet Quickly After Water Damage: Expert Tips
How to Dry a Wet Carpet Quickly After Water Damage: Expert Tips How to Handle Water Damage from Washing Machines: Effective Solutions and Prevention
How to Handle Water Damage from Washing Machines: Effective Solutions and Prevention How to Handle Water Damage After a Storm: A Step-by-Step Guide
How to Handle Water Damage After a Storm: A Step-by-Step Guide Water Damage Restoration After Sewer Flooding: What You Need to Know
Water Damage Restoration After Sewer Flooding: What You Need to Know